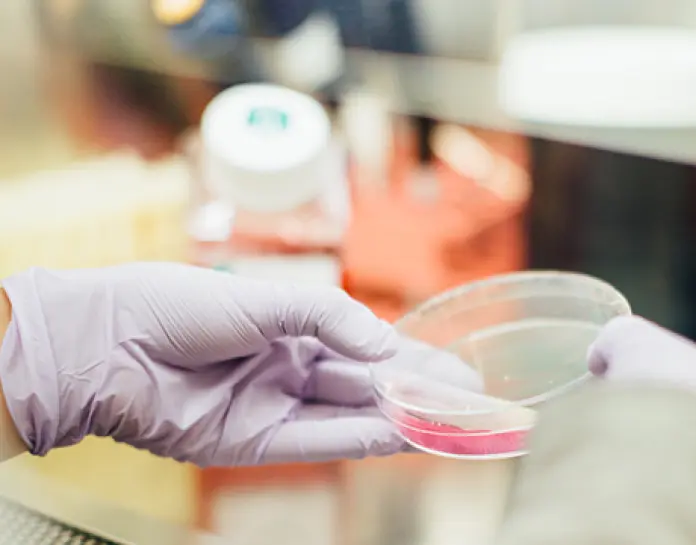
COVID-19: Key aspects for companies, financial institutions and funds

Updated summary of the measures implemented to tackle the effects of the COVID-19
This document is intended to provide companies, financial institutions and funds with an overview and a clear perspective of the measures implemented by the Spanish government to tackle the effects of COVID-19.
We will update it regularly as the situation evolves.